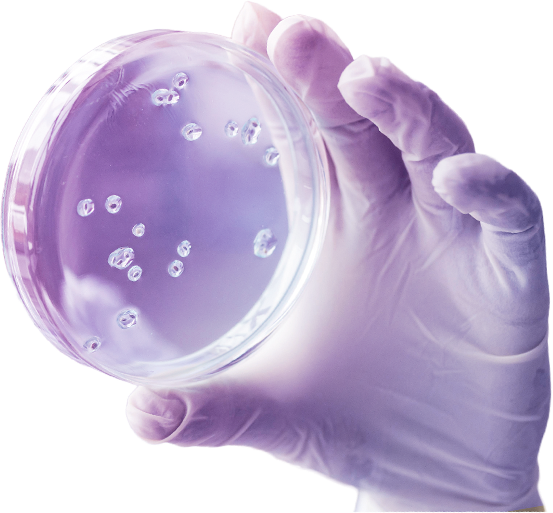

Наши преимущества
-

Анонимность
Для нас приоритетом является безопасность наших клиентов, поэтому после отправки заказа все данные о клиенте удаляются.

-

Качество
Все споровые отпечатки сделаны в стерильных условиях. Отобраны самые жирные споровые отпечатки.

-

Бонусы
При покупке споровых отпечатков или жидкого мицелия на 4000 рублей 1 отпечаток в подарок. Бесплатная доставка по РФ от 3000 руб.

-

Консультация
Мы есть в telegram. Всегда рады ответить на ваши вопросы. Еще мы открыты к сотрудничеству.

-

Исследования
Наша команда всегда развивается и использует лучшие технологии, которые есть в микологии.

-

Доставка
После заказа, посылка будет отправлена от 2 до 4 дней. По РФ доставка занимает до недели, в другие страны 2-4 недели.
Грибная культура — это
-
Комьюнити
Наша эфемерная обитель пропитана любовью и гармонией. Мы создаем пространство, где наши умы сливаются воедино, образуя сияющий маяк мудрости и вдохновения. Здесь, в нашем святилище волшебства, мы приглашаем вас стать частью этого экстраординарного братства.
-
Инструмент
Если в вашем сердце теплится стремление к исцелению и трансформации, вы сделали верный выбор. Пусть наши грибы-проводники станут вашими союзниками на пути к внутреннему балансу. Даже в случае неудачи, мы не оставим вас в одиночестве. Мы всегда готовы помочь.
Популярные товары

Cambodian
Данный стрейн был обнаружен известным микологом Джоном Алленом в районе храме Ангкор-Ват, во время одной из его поездок в Камбоджу.

Albino A+
Очень красивый и сильный cubensis. Брат rasty white

Plantasia Mystery
Данный штамм отличен тем, что у него достаточно легкий вход в психоделическое состояние, что делает его достаточно привлекательным.

Koh samui
Галлюциногенные грибы Koh Samui распространены на острове Самуй, расположенном в Сиамском заливе (Тихий океан).

B+
Легенда гласит, что В+ был выведен культиватором из Флориды по прозвищу Mr. G, больше о появлении этого штамма на свет ничего не известно.

Jamaica
Жидкий мицелий 10мл. Любит органические вещества, низкий уровень CO2 и не чрезмерную влажность для здорового плодоношения.

Jamaica
Жидкий мицелий 10мл. Любит органические вещества, низкий уровень CO2 и не чрезмерную влажность для здорового плодоношения.

Galindoi
Склеры Galindoi обычно имеют темно-коричневый или черный цвет и покрыты мелкими чешуйками. Они довольно прочные, что позволяет грибу расти даже в суровых условиях.
О магазине
Откройте для себя чудеса нашего магазина. Мы предлагаем не просто споры псилоцибиновых грибов, а путь к трансформации и росту. Доверьтесь нам, и мы вместе сотворим магию.Чудо — вот что питает жизнь. Испытайте его на себе!
Мы — не просто магазин, а грибная культура. Сообщество единомышленников, стремящихся к самопознанию и эволюции. Присоединяйтесь к нам, и вместе мы раскроем ваш потенциал!
Наш магазин - проводник чудес, открытый для всех. Доверься нам, и мы вместе сотворим магию, ведь чудо - это сила жизни.
-
5+
Лет работы
Благодаря опыту, мы можем направлять людей так, чтобы у них возникало минимум ошибок.
-
25+
Видов
У нас собраны самые разные штаммы псилоцибиновых грибов.
-
Наш чат
Перейти в чат -
Наш канал
Перейти на канал
У вас есть вопрос?
Напишите запрос в online-консультатнте




